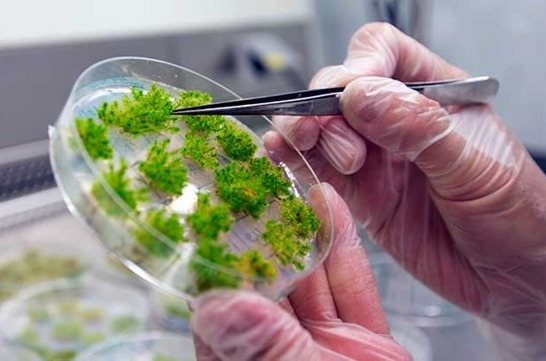

Ribosomet – cellens egen nanofabrikk
Dette er et menneskelig ribosom, en molekylær maskin bygget av RNA og proteiner som jobber med en presisjon og hastighet ingen menneskeskapt teknologi kan matche. Her oversettes genetisk kode til ekte, fungerende proteiner – aminosyre for aminosyre – og alt som skjer i kroppen din starter i denne lille fabrikken.
Proteinsyntesen
Proteinsyntesen er prosessen som gjør genetisk informasjon om til funksjonelle proteiner – molekylene som driver nesten alle livsprosesser. Hver celle er avhengig av kontinuerlig og presis produksjon av proteiner for å kunne vokse, reagere på signaler og opprettholde normale funksjoner.
I denne artikkelen får du en samlet og moderne gjennomgang av hvordan cellen leser DNA, bygger RNA, oversetter kodoner til aminosyrer og regulerer hele prosessen. Samtidig ser vi på mutasjoner, evolusjon av den genetiske koden, energibruk, forskjeller mellom organismer og hva som skjer med proteinet etter at det er laget.
Målet er å gi et klart og helhetlig bilde av hvordan celler bygger livets viktigste molekyler.
Artikkelen er i A4 format. 23 sider.

Kunstig aminosyre – et glimt av fremtidens biologi
Forskere utvikler i dag helt nye aminosyrer som ikke finnes i naturen. En av dem er p‑Azido‑L‑fenylalanin, som har en reaktiv azidogruppe (–N₃) som fungerer som en liten kjemisk "krok". Når den bygges inn i levende celler, kan den kobles til lys, fargestoffer eller nanomaterialer. Og dette er bare én av mange: ulike syntetiske aminosyrer kan gi celler egenskaper som virker hentet fra science fiction – proteiner som lyser i UV‑lys, tåler ekstrem varme, reagerer på magnetfelt eller fungerer som presise molekylære verktøy. Dette er starten på en ny æra der vi ikke bare studerer liv – vi designer det.
Aminosyrer
Aminosyrer er grunnleggende byggesteiner i alt levende. De danner ikke bare proteiner, men deltar også i en lang rekke prosesser som gjør liv mulig – fra energiomsetning og signaloverføring i hjernen til hormonproduksjon, vekst og reparasjon av vev. Selv små variasjoner i aminosyrenes struktur kan gi store forskjeller i egenskaper og funksjon, og derfor er de sentrale både i biologi, medisin, ernæring og bioteknologi. I denne artikkelen utforskes aminosyrenes kjemi, biologiske roller, betydning i helse og sykdom, og hvordan de brukes i moderne teknologi og forskning. Slik får vi et helhetlig bilde av hvorfor disse små molekylene er så avgjørende for livet slik vi kjenner det.
Artikkelen er i A4 format. 26 sider.

Lakselus er en av de største utfordringene i norsk havbruk. Forskere undersøker om genredigering kan brukes til å utvikle laks som er mer motstandsdyktig mot lus, eller til å endre biologien til selve parasitten slik at den ikke lenger kan feste seg på fisken. Målet er å redusere behovet for kjemikalier og behandlinger, styrke fiskehelsen og gjøre oppdrett mer bærekraftig.
CRISPR – genredigeringens tidsalder
CRISPR har på få år gått fra å være et ukjent bakterieforsvar til å bli et av de mest kraftfulle verktøyene i moderne vitenskap. Teknologien gjør det mulig å endre DNA med en presisjon som tidligere var utenkelig – og åpner for alt fra nye medisiner og mer robuste matplanter til helt nye måter å forstå liv på. Samtidig reiser CRISPR store spørsmål om etikk, ansvar og hvordan vi ønsker at fremtidens bioteknologi skal brukes. I denne artikkelen får du en oversikt over hvordan CRISPR fungerer, hva teknologien allerede brukes til, og hvorfor den kommer til å forme både vitenskap og samfunn i årene som kommer.
Artikkelen er i A4 format. 24 sider.

Erteplanten Pisum sativum – Mendels ideelle forsøksorganisme. Arten har selvpollinerende blomster, kort generasjonstid og tydelige, stabile egenskaper som styres av enkeltgener. Den finnes i mange rene linjer (homozygote varianter), noe som gjorde det mulig for Mendel å kontrollere kryssinger og studere én egenskap om gangen. Pisum sativum har over 250 kjente sorter, men Mendel valgte bevisst de som skilte seg i få, klare trekk – perfekt for å avdekke arvelovene.
Gregor Mendel – arvelovens far
Gregor Mendel er en av vitenskapshistoriens mest betydningsfulle skikkelser, men han ble ikke anerkjent i sin egen tid. Denne artikkelen følger reisen hans fra en bondegutt i det østerrikske riket til grunnleggeren av moderne genetikk. Den viser hvordan Mendels utdanning, klostermiljøet i Brünn og hans systematiske arbeid med erteplanter gjorde det mulig å avdekke arvelovene som fortsatt brukes i biologien i dag. Artikkelen forklarer også hvorfor forskningen hans ble oversett, hvordan den ble gjenoppdaget i 1900, og hvordan senere analyser – inkludert den kjente Fisher‑kontroversen – har formet forståelsen av Mendels arbeid. Til sammen gir teksten et helhetlig og moderne bilde av Mendels liv, forskning og vitenskapelige arv.
Artikkelen er i A4 format. 18 sider.

Tobakksrøyk inneholder hundrevis av mutagene kjemikalier som skader DNA i luftveiene. I lungecellene til en storrøyker kan man finne titusenvis av ekstra mutasjoner sammenlignet med en ikke‑røyker – et mønster som øker risikoen for lungekreft og andre alvorlige sykdommer.
Hva er en genmutasjon?
Genmutasjoner er grunnlaget for all biologisk variasjon – fra evolusjon og artsdannelse til sykdomsutvikling og moderne genteknologi. I denne artikkelen får du en helhetlig og oppdatert gjennomgang av hva mutasjoner er, hvordan de oppstår, hvordan cellene forsøker å reparere dem, og hvorfor de noen ganger får store konsekvenser. Du får også innsikt i alt fra CRISPR og epigenetikk til mitokondrielt DNA, kreftgenomikk og virusmutasjoner. Artikkelen er skrevet for elever, lærere og alle som ønsker en dypere forståelse av genetikk og bioteknologi – forklart på en klar og tilgjengelig måte.
Artikkelen er i A4 format. 20 sider.
Planter brukes som modellorganismer for å forstå hvordan gener styrer vekst, utvikling og stressrespons. I Norge forskes det på planter for å utvikle mer robuste, klimabestandige og bærekraftige mat- og nyttevekster.
Hvorfor forskere bruker modellorganismer
Denne artikkelen gir en oversikt over hvorfor forskere bruker modellorganismer – alt fra bakterier og gjær til planter, rundormer, insekter, fisk, amfibier og pattedyr – for å forstå hvordan liv fungerer. Ved å studere enklere organismer kan forskere avdekke grunnleggende mekanismer i gener, celler, utvikling og sykdom, og slik bygge kunnskap som også gjelder for mennesker. Artikkelen viser både den vitenskapelige betydningen av modellorganismer og de etiske spørsmålene som følger med bruken av dem.
Artikkelen er i A4 format. 25 sider.
